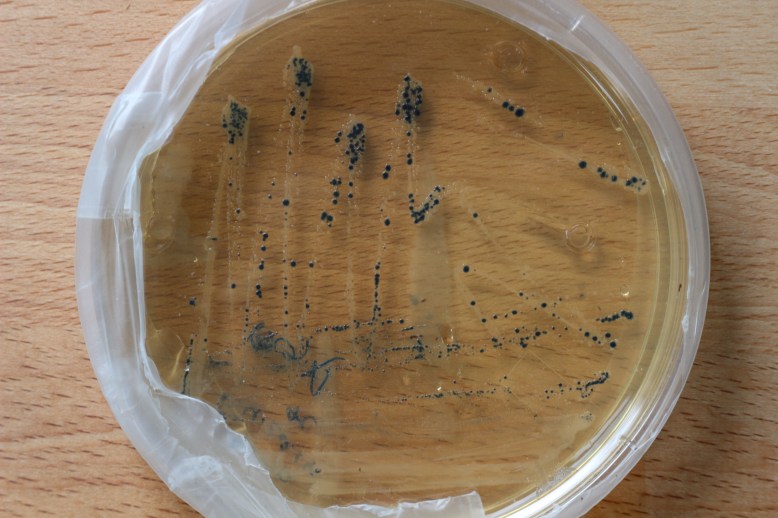
IMG_5478

Last year I got an awesome grant to work on the bluegene project. Awesome grants are by definition, awesome. For those who don’t know, an awesome foundation grant is a no strings attached $1k grant. They are granted one a month by decision of the awesome foundation trustees, who each put up $100 towards the grant. As a result, are very flexible, community oriented, and can support all kinds of projects. In my case, the awesome grant allowed me to work on project bluegene.
Project blugene is a project to increase the yield of indigo from genetically modified e coli. The e coli harbors a plasmid that contains the sequence fpr a monoxygenase from rhodococcus. This enzyme acts on indole, turning it into indoxyl, which spontaneously turns into indigo in the presence of oxygen.
So what happened to the grant money? What has happened in bluegene? The answer is that a lot has been done, but not much has changed. Unlike mechanical or electrical engineering, bioengineering has a much slower and much more expensive turnaround time on prototypes. To make sweeping generalizations, a programming project will generate almost instantaneous feedback when run, and takes hours to iterate on, mostly for free. A pcb design might take a few (2-3) days to fabricate and test. A small mechanical prototype can be cranked out in a week, but feedback can be generated as it is built. Implicit in all these things are feedback tools built on hundreds of years of innovation and iteration, from compiler debug output, multimeters, and logic analyzers to micrometers, thread gauges and coordinate measuring machines.
Biology has none of this. Debugging is hard, and the parts are for all intents and purposes, invisible. Things are getting slightly better (cheap sequencing, qPCR), but its nowhere near the level of ease of a micrometer or o-scope yet. And with school in session and a 6 hour round trip commute to the lab, the amount of time I have put in is less than I want. The result is that the gene was modified, with the result of only disrupting and not improving the function of the gene. This was a result of trusting the sequence from the paper, instead of the more contemporary sequence from the plasmid I had. It was a stupid error, but it seemed straightforward at the time.
The approximate cost breakdown is :
- $200 for restriction enzymes and exonuclease
- $65 for a plasimid prep kit
- $80 for ligase
- $80 pcr/gel extraction kit
- $80 error correcting pcr master mix
That comes out to $500 for one iteration, not including DNA sequencing, PCR primers, lab consumables like DNA stains, agarose, media, pipette tips, petri dishes, or microtubes. Doing the cutting, pasting, and testing is also incredibly time intensive and pretty boring. While it is theoretically exciting that your DNA is being copied thousands of times by amazing enzymes, it is not exciting to sit on a couch and wait for it. The waiting time and the cost make it expensive to iterate and improve designs.
However, there is a technical solution to the problem. The toolset I was using on the project was based in molecular biology, and fundamentally comes down to cutting, pasting, and copying pieces of DNA. At the time, it was a cheaper tool-set by maybe $200 compared to DNA synthesis. But that was a year or so ago.
In the last year the cost of 1kb+ (kilobases, not kilobytes) DNA synthesis has plummeted. There used to be extra costs associated with genes over 1kb in ligation and in wastage of the ends of the synthesis. Now, both life and IDT are offering cheap synthesis of genes in excess of 1kb. Life technologies offers up to 3kb and IDT oferers up to 2kb genes. IDT even offers MIXED BASES, allowing you to have random mutations in certain portions of your gene.
The price for the gene that I spent $500+ and many hours unsuccessfully modifying now only costs about $210 bucks, and I can have it in a few days instead of after a few weeks. That price and turn time are about the same price as a small quick-turned PCB. While the debug tools are not quite there yet, biological prototyping is really catching up to other engineering disciplines. Clearly the next move is to get the DNA synthesized, and try it out!